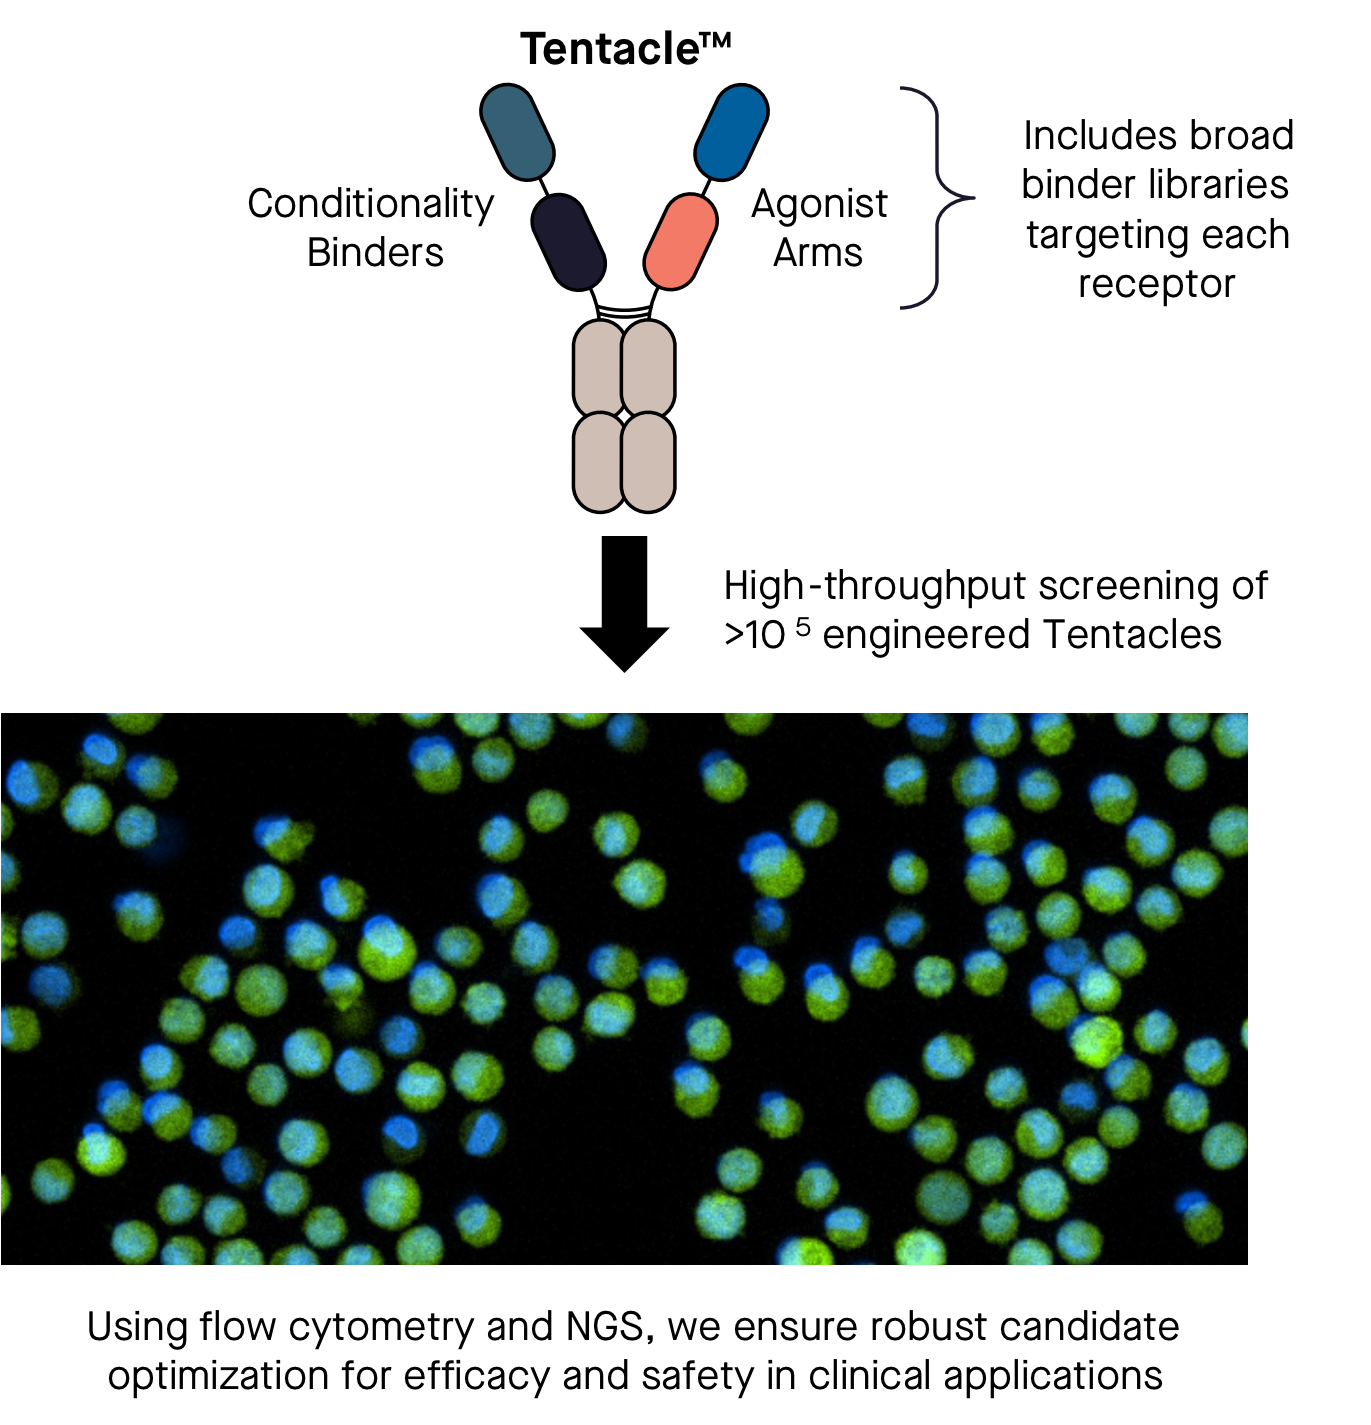

Introducing the
Tentarix platform
Our Science Begins Where
Traditional Biologics Fall Short
VH-Select™
Building Stable, Fully Human Scaffolds
Our proprietary VH-Select™ technology encompasses all 47 functional human VH genes, engineered for exceptional thermal stability and developability, laying the foundation for safer, more effective biologics.

FunctionSeq™
Screening for Optimal Conditional Activity
FunctionSeq™ is our mammalian display and flow cytometry-based screening platform that enables high-throughput discovery of Tentacles™ with precise conditionality and optimized function.

Tentacles™
Targeting the Right Cells at the Right Time
Tentacles™ are multifunctional, conditionally active molecules designed to selectively engage specific cell types, enabling powerful therapeutic effects while avoiding systemic toxicity.

Unique in the Industry: Stabilized Human VHs
Overcoming historical challenges with single-domain binders that limit other platforms
Industry standard: Camelid VHH (Nanobody)
Camelid VHH binders are a common industry scaffold
Challenges:
Lengthy immunizations
Limited repertoires
Humanization required
Immunogenicity
Emerging scaffold: Fully Human VH
Human VH rodents have been developed as an emerging scaffold
Challenges:
Low VH stability requires engineering
Limited VH diversity
VH binding to antibody light chains
VH homodimerization


VH-Select™
Differentiated and Stabilized Fully Human VH Binders
Little to no engineering of binders required: improves probability of success and shortens R&D timelines
Patent application filed that covers stabilization of all 47 functional VH domains in the human genome (encompassing all germline VH families, VH1–VH7)


FunctionSeq™
Discovering Tentacles with optimal activity and cell specificity requires building and screening large Tentacle libraries (>10⁵) inaccessible to most screening platforms
Tentarix leverages mammalian display to functionally evaluate large Tentacle libraries with the capacity to investigate:
Varied binder epitope and affinities
Varied Tentacle geometries
Varied linker lengths
Mammalian Display Reporter System for Identifying
Conditional Agonists (Tentacles™)
Proof-of-Concept Agonist with >1,000x Conditionality

